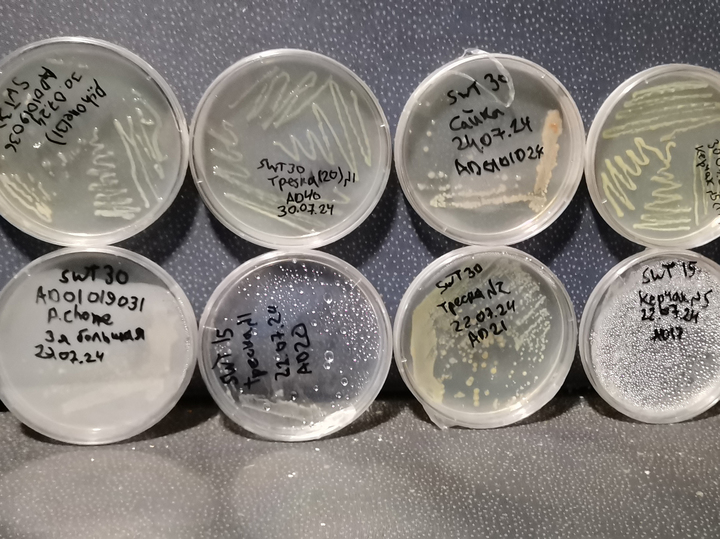

Потепление не прекращается
Атлантификация, то есть потепление Арктики под воздействием теплых вод Северной Атлантики, продолжается. Это подтвердили последние данные, полученные российскими учеными во время поездки в самые северные моря Земли. Они также выяснили, что в тех же морях начали размножаться грибы… . Участники экспедиции рассказали обозревателю «МК» о самом интересном, что удалось обнаружить во время экспедиции в Карское море и море Лаптевых.
 Вид на льды Карского моря с борта научно-исследовательского судна «Профессор Молчанов». Автор О. Мерзлякова
Вид на льды Карского моря с борта научно-исследовательского судна «Профессор Молчанов». Автор О. Мерзлякова
Почему Арктика так интересна исследователям? Потому что это регион, где потепление происходит гораздо быстрее, чем в других местах планеты. Если в среднем температура воздуха на Земле с конца XIX века (начала индустриальной эпохи) выросла на 1 градус, то в Арктике за это время она потеплела в среднем на 2-3 градуса, а в некоторых районах даже больше, на 6-7 (!) градусов. С начала 2000-х годов льды в Северном Ледовитом океане начали стремительно отступать, на 13% каждое десятилетие. Тогда казалось, что пройдет совсем немного времени и уже в 2020-2030-х годах Арктика будет полностью свободна ото льда летом. Но природа снова подбросила загадку — теперь льды стабилизировались! После минимума 2012 года, когда в Арктике к концу теплого сезона осталось всего 3,4 млн квадратных километров льда (это вдвое меньше среднего показателя в 6-8 млн квадратных километров в конце XX века), стремительное таяние внезапно прекратилось. Все последующие экспедиции обнаружили, что площадь, покрытая льдом летом и осенью, стабилизировалась, и никто пока не может сказать, почему это так. Конечно, речи об увеличении ледового покрова тоже не идет; За последнее десятилетие площадь ледяного покрова Арктики не превышала 4-5 миллионов квадратных километров, но рекорд 2012 года пока не побит.
 НИС «Профессор Молчанов». Автор О. Мерзлякова
НИС «Профессор Молчанов». Автор О. Мерзлякова
Тем временем Северный морской путь немного медленнее, но он «раскрывается», и теплое течение из Атлантики, продолжение Гольфстрима, проникает глубже в Арктику. Эти масштабные водные потоки требуют изучения, так как от них зависит будущая экологическая перестройка в регионе.
Последняя экспедиция в Арктику на научно-исследовательском судне «Профессор Молчанов», которая стартовала из Архангельска 20 июля, имела одной из своих целей — изучение особенностей этих течений. В течение 41 дня до окончания экспедиции в конце августа в Тикси специалисты Института океанологии (ИО РАН), Московского физико-технического института (МФТИ) и МГУ проводили исследования водных масс на шельфе и континентальном склоне морей Российской Арктики. В состав экспедиции вошли 20 ученых и 26 студентов.
Если в предыдущие годы экспедиции Плавучего университета работали в западных районах Арктики, то география новой в 2024 году расширилась на восток. Исследователи работали на континентальном склоне в Карском море и море Лаптевых, где особенно ярко выражены изменения климата.
– Почему же все-таки в Арктике теплеет? – спрашиваю я руководителя научных работ экспедиции, доктора физико-математических наук, ведущего научного сотрудника ИО РАН, заведующего лабораторией Арктической океанологии МФТИ Александра ОСАДЧИЕВА.
– Ключ к пониманию этого вопроса лежит в двух плоскостях – атмосферные условия (температура воздуха и ветер) и течение атлантических вод. Мы имеем дело с морем. Из Северной Атлантики в Арктику идет тепловой поток, наш любимый Гольфстрим, который начинается в тропиках, перетекает через Атлантику, затем часть его разделяется и течет вдоль Норвегии и далее в Баренцево море. Затем его путь продолжается вокруг всей Арктики – вдоль Сибири, Аляски, Канады, и он возвращается обратно в Северную Атлантику вдоль Гренландии.
Мы хорошо знаем характеристики воды на входе в Баренцево море. Это место называется «Кольским меридианом», где море еще не замерзло, и регулярные измерения там проводятся уже более ста лет. На входе в Баренцево море температура сейчас составляет 4-5 градусов (в 1980-х годах она составляла 3-3,5 градуса). Но что происходит с атлантической водой дальше, как меняются ее свойства, как происходит теплообмен с поверхностными арктическими водами, мы знаем гораздо меньше. А это важно для прогнозирования дальнейших изменений, в первую очередь ледовой обстановки.
 Исследователи с НИС «Профессор Молчанов». Автор О. Мерзлякова
Исследователи с НИС «Профессор Молчанов». Автор О. Мерзлякова
Раньше считалось, что эти воды текут по склону и постепенно остывают, отдавая свое тело. И это взаимодействие атлантических вод с поверхностными водами Арктики считалось важнейшим фактором, влияющим на их температуру. То есть все имели в виду два процесса: они пропускают теплый поток в Арктику, и он постоянно остывает. Но мы увидели во время экспедиции, что изменчивость внешних условий очень зависит от изменчивости температуры атлантических вод на входе в Баренцево море.
– Логично, но в предыдущих моделях этот фактор никто не учитывал. Было мнение, что вода одна и та же и просто постепенно остывает, проходя по континентальному склону. На самом деле атлантические воды в разные годы очень разные, и их изменчивость важнее самого процесса охлаждения.
– Да. Бывает, что определенные районы остаются покрытыми льдом круглый год. Например, в районе мыса Челюскин между Таймыром и архипелагом Северная Земля находится самое узкое место на нашем Северном морском пути – как правило, лед там тает очень поздно. Бывает, что весь лед на Северном морском пути уже растаял, и этот узкий пролив остается подо льдом и затрудняет движение – нужен ледокол. На протяжении всего 20 века там были суровые ледовые условия, а с потеплением сейчас случается, что этот пролив свободен ото льда в течение двух месяцев.
– В этом году этот пролив освободился рано, в целом лед отступил довольно далеко, и мы дошли до желоба Воронина до 81 градуса северной широты, до полюса оставалось меньше 1000 км. А в 2021 году мы вообще не смогли работать в этом районе, лед простоял там весь теплый сезон и не пропускал наше судно.
Он все больше становится похож на Северную Атлантику, свободную ото льда, даже зимой. Раньше значительная его часть была покрыта льдом, сейчас он незначительный, только на востоке. Естественно, по мере продвижения в теплые воды туда попадают и биологические виды, более характерные для Северной Атлантики.
Биолюминесцентные бактерии в чашках Петри при дневном свете. Автор А. Лехнович.
Биолюминесцентные бактерии в чашках Петри при дневном свете. Автор А. Лехнович.
Много работы в экспедиции было и у биологов. Они изучали микробные пищевые сети прибрежных вод архипелагов Новая Земля и Северная Земля. В частности, была обнаружена большая разница в видовом составе и численности микробных сообществ в Карском море и море Лаптевых. По словам биолога из МГУ имени М. В. Ломоносова Ольги КОНОВАЛОВОЙ, это важно для прогнозирования биологической продуктивности в условиях продолжающегося потепления и сокращения ледового покрова.
– Мы впервые обнаружили биолюминесцентные бактерии в кишечнике арктических рыб и морских беспозвоночных, – говорит биолог. – Ранее было известно только три их вида, и возможно, что мы открыли новый.
– У наваги, у северного бычка.
– Их используют для создания генетических инструментов, например, для выделения движения генов с белком этих бактерий при генно-инженерных операциях. Есть гипотеза, что бактерии начинают светиться при высоких концентрациях. Дело в том, что у них есть так называемое чувство общности, или чувство кворума.
– Да, мы посеяли их прямо на корабле – 7 из 43 культур в чашках Петри дали такое свечение в темноте!
– В этой экспедиции мы изучали не грибы, а морских грибовидных протистов (организмы, не входящие в состав животных, грибов и растений. – Авт.). Раньше их изучали только в теплых морях и в Белом море. В Карском и Лаптевых морях мы их обнаружили впервые. Для Арктики их оказалось довольно много. Это существа, которые могут либо просто питаться мертвой органикой, либо паразитировать на других существах. Например, они встречаются на фитопланктоне, на ракообразных. Протисты могут доставлять неприятности экосистеме и человеку, например, в теплых морях они иногда вызывают эпизоотии в аквакультуре, разрастаясь в жабрах устриц (они становятся черными) и убивая их. Но они также могут быть полезны, поскольку образуют биоактивные вещества.
 Биолюминесцентные арктические бактерии светятся в темноте. Автор А. Лехнович.
Биолюминесцентные арктические бактерии светятся в темноте. Автор А. Лехнович.
– Мы пытались поймать что-нибудь удочкой в море Лаптевых. Иногда попадалась только сайка, которую ласково называли сайкой. Но в целом рыбалка в восточной Арктике – занятие бесполезное – рыбы тут очень мало. Баренцево море в этом смысле более продуктивно.


